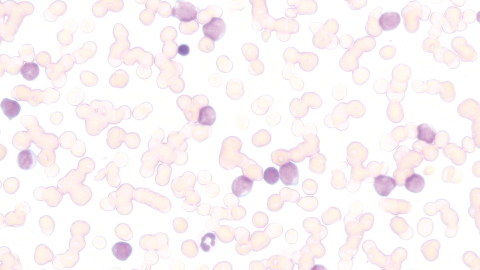

Fokus auf Komfort. Komfort im Fokus.
Nikons Leitgedanke bei der Entwicklung des Labormikroskops ECLIPSE Si war stets, den anspruchsvollen Anforderungen von Expertinnen und Experten gerecht zu werden, die tagtäglich sehr viel mikroskopieren.
Das ECLIPSE Si ist so ergonomisch gestaltet, dass das gesamte Arbeitserlebnis bei der Mikroskopie deutlich verbessert ist. Dieses leistungsstarke Mikroskop hilft Ihnen, länger konzentriert auf das Mikroskopieren zu bleiben, indem die körperlichen Beanspruchungsparameter reduziert werden.
Das ECLIPSE Si ist der neue Standard für die tägliche Labormikroskopie und erweitert die Möglichkeiten mikroskopischer Untersuchungen.
Hauptmerkmale
Auf effiziente workflows hinarbeiten
Das primäre Ziel bei der Entwicklung des ECLIPSE Si war, die körperlichen Beanspruchungs- und Ermüdungserscheinungen beim Mikroskopieren zu minimieren. Das ECLIPSE Si vermeidet unnötige Haltungsanpassungen und ermöglicht eine komfortable und damit effizientere Mikroskopie. Das ergonomische Design lässt die Beibehaltung einer natürlichen Körperhaltung selbst dann zu, wenn sich wiederholende Aufgaben ausgeführt werden.

Beibehaltung einer angenehmen Helligkeit beim Umschalten der Vergrößerung
Objektive mit unterschiedlichen Vergrößerungen lassen Licht in unterschiedlichem Maße durch. Daher muss die Lichtintensität jedes Mal angepasst werden, wenn das Objektiv gewechstelt wird. Wenn Sie von Objektiven mit hoher zu niedriger Vergrößerung wechseln, führt die plötzliche Erhöhung der Helligkeit häufig dazu, dass die Augen geblendet werden, was sie auf die Dauer ermüdet. Das ECLIPSE Si verfügt über das intelligente Lichtintensitätsmanagement (LIM), welches die Lichtintensitätsstufe für jedes Objektiv individuell speichert und entsprechend wieder abruft und einstellt. Diese LIM-Funktion reduziert den Zeitaufwand für die händische Anpassung der Lichtintensität nach jedem Objektivwechsel auf bis zu 40%*. Mit dem ECLIPSE Si wird das Mikroskopieren bequemer und man spart Zeit, auch dann, wenn die Routine häufige Vergrößerungswechsel erfordert.
* Im Vergleich zu einem früheren LED-Modell hinsichtlich der Zeit, die erforderlich ist, um zwischen drei Objektiven zu wechseln und die Lichtintensität jeweils von Hand anzupassen (Test von Nikon durchgeführt)

Bei ausgeschalteter LIM-Funktion
Da die Helligkeit je nach Objektiv variiert, können Vergrößerungswechsel zu einer Belastung der Augen führen.

Bei aktivierter LIM-Funktion
Für jedes Objektiv ist die jeweils optimale Lichtintensitätsstufe gespeichert, die sich beim Einschalten in den Strahlengang automatisch einstellt. Dadurch werden unvermittelte Helligkeitsunterschiede beim Objektivwechsel unterbunden, was die Augen schont und den workflow entspannt.


Tief gelegter Kreuztisch
Das Niveau des Kreuztisches liegt bei 135 mm und damit beim ECLIPSE Si etwa 50 mm niedriger als bei unseren herkömmlichen Mikroskopen. Dadurch wird der Bewegungsumfang für die Arme und Hände beim Präparatwechsel erheblich reduziert und beugt unnötiger Ermüdung der Arme und Schultern vor. Da die Fokusknöpfe ebenfalls niedriger liegen, können beim gründlichen Durchmustern der Präparate Ihre Unterarme und Ihre Hände entspannt auf dem Tisch liegen. Der Federhebel des Präparatehalters bekam ebenfalls eine ergonomische Form, um beim Wechseln der Präparate einfacher mit ihm hantieren zu können. Das Wechseln der Objektträger wird auch dadurch optimiert, dass der Kreuztisch des ECLIPSE Si eine 30% kleinere Fläche als bei unseren herkömmlichen Mikroskope ausmacht.


Eine entspannte, natürliche Körperhaltung beim Mikroskopieren wird beibehalten
Der Binokulartubus hat einen Einblickwinkel von 45 Grad, sodass beim Blick durch die Okulare eine natürliche Kopf- und Körperhaltung beibehalten wird. Ohne diese bequeme Haltung ändern zu müssen haben Sie auch schnell - mit einem Augendreh von den Okularen nach unten - die Positionierung des Präparates auf dem tief liegenden Kreuztisch gecheckt. Um gegebenenfalls die Höhe des Einblicks in die Okulare individuell anzupassen, steht ein Distanzstück ("eye-level riser") zur Verfügung.


Kein riskantes Fokussieren dank vertikalem Höhenanschlag
Das ECLIPSE Si hält einen Höhenanschlag bereit, mit dem eine Obergrenze für den Kreuztisch eingestellt werden kann ("FOCUS LIMIT"). Der Tisch stoppt am definierten Limit, auch wenn der Fokustrieb weitergedreht wird. Dadurch wird vermieden, dass durch unbedachtes "Überfokussieren" der Objektträger mit dem Objektiv kollidiert, und - schlimmstenfalls sogar beide - beschädigt werden. So sind mit dem Si sowohl die Präparatwechsel als auch das Fokussieren absolut risikolos - man muss sich um die Tischhöhe nicht kümmern.


Entspannte Bedienung
Wir wollten ein Mikroskop entwickeln, das keine Ermüdungserscheinungen durch häufigen Präparatwechsel aufkommen und ein angenehmes Arbeitserlebnis erfahren lässt. Das ECLIPSE Si kombiniert innovative Funktionen und intelligentes Design, um unnötige Körperbewegungen zu supprimieren, Zeit zu sparen und den Benutzer zu entlasten, selbst wenn sehr viele Objektträger zu untersuchen sind.
Fokus und Kreuztisch mit einer Hand im Griff
Die Grob- und Feinfokusknöpfe befinden sich auf beiden Seiten des Mikroskops und ermöglichen das Fokussieren mit beiden Händen. Darüber hinaus befindet sich der koaxiale Kreuztischgriff ganz in der Nähe des Fokusknopfs, sodass Benutzer die Tischposition und den Fokus problemlos mit ein und derselben Hand einstellen können. Wenn die XY-Tischbewegung und der Fokus von ein und derselben Hand gesteuert werden, kann die andere Hand zum Drehen des Objektivrevolvers oder zum Wechseln der Objektträger verwendet werden. Diese Funktionalitäten bieten einen effizienten Arbeitsablauf, selbst wenn eine große Anzahl von Objektträgern zu untersuchen ist.

| Grobfokus | Feinfokus |

Grob- / Feinfokus und XY-Tischbewegung können mit einer Hand bedient werden
Statusanzeige
Auf dem LCD am Stativfuß ist mit Anzeigebalken die jeweils eingestellte Beleuchtungshelligkeit zu erkennen. Dort ist auch die aktive Objektivvergrößerung mit einen Blick gecheckt, ohne dass Sie Ihre Beobachtungshaltung ändern müssen.
❶ECO-Modus: Ein ❷LIM-Funktion: Ein ❸Objektname ❹Vergrößerung ❺Helligkeitszustand

Entspannte Bedienung
Wir wollten ein Mikroskop entwickeln, das keine Ermüdungserscheinungen durch häufigen Präparatwechsel aufkommen und ein angenehmes Arbeitserlebnis erfahren lässt. Das ECLIPSE Si kombiniert innovative Funktionen und intelligentes Design, um unnötige Körperbewegungen zu supprimieren, Zeit zu sparen und den Benutzer zu entlasten, selbst wenn sehr viele Objektträger zu untersuchen sind.
Fokus und Kreuztisch mit einer Hand im Griff
Die Grob- und Feinfokusknöpfe befinden sich auf beiden Seiten des Mikroskops und ermöglichen das Fokussieren mit beiden Händen. Darüber hinaus befindet sich der koaxiale Kreuztischgriff ganz in der Nähe des Fokusknopfs, sodass Benutzer die Tischposition und den Fokus problemlos mit ein und derselben Hand einstellen können. Wenn die XY-Tischbewegung und der Fokus von ein und derselben Hand gesteuert werden, kann die andere Hand zum Drehen des Objektivrevolvers oder zum Wechseln der Objektträger verwendet werden. Diese Funktionalitäten bieten einen effizienten Arbeitsablauf, selbst wenn eine große Anzahl von Objektträgern zu untersuchen ist.

| Grobfokus | Feinfokus |

Grob- / Feinfokus und XY-Tischbewegung können mit einer Hand bedient werden
Statusanzeige
Auf dem LCD am Stativfuß ist mit Anzeigebalken die jeweils eingestellte Beleuchtungshelligkeit zu erkennen. Dort ist auch die aktive Objektivvergrößerung mit einen Blick gecheckt, ohne dass Sie Ihre Beobachtungshaltung ändern müssen.
❶ECO-Modus: Ein ❷LIM-Funktion: Ein ❸Objektname ❹Vergrößerung ❺Helligkeitszustand

Richtungsanzeige an den Drehknöpfen
An den Fokustrieben und am Helligkeitsregler sind mit eindeutigen Pfeilen die jeweiligen Drehrichtungen deutlich sichtbar angezeigt.

Sofort die Hand am richtigen Knopf
Auf dem Kreuztisch gut sichtbar bei der entsprechenden X- bzw. Y-Nonius-Skala illustrieren Icons die jeweiligen Knöpfe des Koax-Tischtriebes, welcher für die entsprechende Richtung gedreht werden muss.

Bequemer Vergrößerungswechsel
Der nach hinten geneigte Objektivrevolver bietet freien Zugang und Blick zum Objektiv im Strahlengang. Der Objektivrevolver liegt relativ niedrig, um für die Objektivwechel die Hand zum Drehen nicht zu hoch heben zu müssen. Der Objektivrevolver hat einen griffigen Handring, einen angenehmen Rotationswiderstand, präzise click-stopps und nimmt bis zu fünf Objektive für fein-abstufbare Vergrößerungsreihen auf.

Leicht zu drehender 5-fach Objektivrevolver
Blockiert zu viel Blau im LED-Licht
Der relativ große Anteil an blauem (kurzwelligem) Licht von LED-Leuchten führt bei längerem Hineinschauen zu Belastungen der Augen. Für das ECLIPSE Si gibt es optional einen Blaulicht-Sperrfilter, der auf das Glas über der Leuchtfeldblende aufgelegt werden kann, um die blaue Komponente des LED-Lichts relativ stark zu unterdrücken.

Automatische Licht-Aus-Funktion
Das ECLIPSE Si hat einen ECO-Modus, der die Beleuchtung nach einem bestimmten Zeitintervall kompletter Inaktivität am Mikroskop automatisch ausschaltet. Die Länge der Inaktivitätsperiode ist einstellbar. Mit dem ECO-Modus des ECLIPSE Si sparen Sie automatisch Strom.

Halten Sie den Helligkeitsregler für einen Augenblick gedrückt, um den ECO-Modus einzuschalten.


Exzellente Optik für hochwertige Bilder
Nikon's fortschrittliche optische Technologien, die auf einer langen Tradition als ein führender Mikroskophersteller beruhen, spielen eine wichtige Rolle beim ECLIPSE Si. Die Fähigkeit, höchste Anforderungen an hochwertigste Abbildung der Proben zu erfüllen, erfüllt uns mit Stolz.
Hervorragende Bildfeldebnung und Korrektur chromatischer Aberration
Das ECLIPSE Si verwendet Objektive der CFI E Plan-Serie, die geebnete, scharfe Bilder bis in die Ränder des Sehfeldes liefern. Diese Objektive sind Teil des unendlich korrigierten optischen Systems CFI60, das sowohl hohe Auflösung als auch lange Arbeitsabstände verwirklicht. Eine Vielzahl von Nikon CFI60-Objektiven steht zur Auswahl.

Mikroskopie im großen Sehfeld 22 mm
Insbesondere bei klinischen Mikroskopie-Anwendungen kann das ECLIPSE Si die Effizienz steigern, wenn es mit Tuben und Objektiven für Sehfeld 22* ausgestattet wird.
* Binokulartuben C-TB-, C-TF-, C-TT- und C-TE2

Langlebige LED mit konstanter Farbtemperatur
Die leuchtstarke, weiße LED-Lichtquelle bietet eine lange Lebensdauer von bis zu 60.000 Stunden. Da auch bei Änderung der Helligkeit die Farbtemperatur konstant bleibt, ändert sich diese auch beim Ändern der Vergrößerung nicht.


Gleichmäßige Helligkeit bis in die Ränder des Sehfeldes
Die im Beleuchtungssystem des ECLIPSE Si integrierte Fly-Eye-Linse bewirkt eine wunderbar homogene Ausleuchtung über das gesamte Sehfeld.

Effektiv Streulicht von außerhalb des Sehfeldes blockieren
Das ECLIPSE Si hat eine Leuchtfeldblende, mit der der Querschnitt des Beleuchtungsstrahlbündels für eine optimale, visuelle Beobachtung und Kameraaufnahme sauber begrenzt werden kann. Durch das korrekte Einstellen der Leuchtfeldblende werden Streulicht und unerwünschte Randeffekte (z.B. Ghosting) unterdrückt, wodurch kontrastreiche, fehlerfreie Bilder entstehen. Bei Fluoreszenzmikroskopie kann der Bereich, in dem ein Photobleichen auftritt begrenzt werden.

Kompatibel mit einer Vielzahl von Mikroskopiertechniken
Durch optionales Zubehör kann das ECLIPSE Si über die Hellfeld-Beleuchtung hinaus für eine Vielzahl von Beobachtungsmethoden ausgestattet werden.
Hellfeld
Die Objektive mit exzellenter Bildfeldebnung und ausgezeichneter Korrektur chromatischer Aberration ergeben hochwertige, und über das gesamte Sehfeld homogen ausgeleuchtete, helle Bilder.

Phasenkontrast
Combining of a phase condenser and phase contrast objectives enables observation of colorless and transparent specimens with high contrast, without staining or labeling the specimens with dyes. A standard Abbe condenser, with a PH slider inserted, also allows phase contrast observation.


❶ CFI DL phase contrast objectives, ❷ GIF filter, ❸ Centering telescope
And either:
❹ Phase contrast sliders (set of 2) or ❺ Phase Condenser with Condenser height adjustment tool
Durchlicht-Fluoreszenzmikroskopie
Nikon hat eine einzigartige Methode für die Durchlicht- Fluoreszenzmikroskopie entwickelt, mit der viele einfache Fluoreszenzuntersuchungen möglich sind, ohne dass eine spezielle Auflicht-Beleuchtungseinrichtung und weiteres Fluoreszenzequipment eingerichtet werden muss. Durch einfaches Einsetzen eines Anregungs-Filterschiebers (Excitation) in den Kondensor und eines Sperr-Filterschiebers (Barrier) in den Objektivrevolverschlitz können Fluoreszenzuntersuchungen an Proben durchgeführt werden, die GFP exprimieren oder mit Fluoreszenzfarbstoffen wie FITC und Alexa 488 gefärbt sind.
Filtersatz für Durchlicht-Fluoreszenzmikroskopie
Online-Anleitung mit einem Smartphone zugänglich
Die leicht verständliche Anleitung zum ECLIPSE Si ist im Nu über das Scannen des QR-Codes auf dem Sticker am Mikroskopstativ über die entsprechende website verfügbar. So ist es jederzeit möglich, sich über eingängige Videos und Bilder mit der Bedienung und mit der Einstellung von Mikroskopiertechniken vertraut zu machen. Klicken Sie hier, um direkt auf das Online-Handbuch zuzugreifen.
* QR-Code ist eine eingetragene Marke von DENSO WAVE INCORPORATED.
Jederzeit schnell und einfach verstaut
Bei der Entwicklung des Si hat man auch darauf geachtet, dass das Mikroskop nach getaner Arbeit schnell und sicher verstaut werden kann. Neben dem leichten, griffgünstigen Design hat das ansprechende Stativ auf seiner Rückseite auch eine praktische Vorrichtung fürs Aufwickeln des Stromkabels.
Leicht zu tragen
Das Stativ des ECLIPSE Si ist um 14% leichter als das des Vorgängermodells*. Griffmulden auf beiden Seiten der Mikroskopbasis und der hinteren Arme lassen das Mikroskop leicht und sicher tragen. Darüber hinaus können die Okulare mit Schrauben sicher befestigt werden, damit sie beim Transport nicht herunterfallen.
* Mit LED
Sicher verstauen
Zum Verstauen lässt sich der Tubus durch einfaches Lösen einer Feststellschraube nach hinten drehen, wodurch der Stauraum fürs Mikroskop nochmal kleiner wird. Der Tubus ist so konstruiert, dass er nach Lösen der Feststellschraube nicht herunterfallen kann. Die Drehrichtung für den Tubus ist deutlich auf dem Stativ angezeigt.
Auf der Rückseite des Mikroskops ist das Netzteil ordentlich in einem Fach verstaut und das Stromkabel auf die praktische Hantelspange gewickelt.
Durchlicht-Fluoreszenzmikroskopie
Nikon hat eine einzigartige Methode für die Durchlicht-Fluoreszenzmikroskopie entwickelt, mit der viele einfache Fluoreszenzuntersuchungen möglich sind, ohne dass eine spezielle Auflicht-Beleuchtungseinrichtung und weiteres Fluoreszenzequipment eingerichtet werden muss. Durch einfaches Einsetzen eines Anregungs-Filterschiebers (Excitation) in den Kondensor und eines Sperr-Filterschiebers (Barrier) in den Objektivrevolverschlitz können Fluoreszenzuntersuchungen an Proben durchgeführt werden, die GFP exprimieren oder mit Fluoreszenzfarbstoffen wie FITC und Alexa 488 gefärbt sind.


Online-Anleitung mit einem Smartphone zugänglich
Die leicht verständliche Anleitung zum ECLIPSE Si ist im Nu über das Scannen des QR-Codes auf dem Sticker am Mikroskopstativ über die entsprechende Website verfügbar. So ist es jederzeit möglich, sich über eingängige Videos und Bilder mit der Bedienung und mit der Einstellung von Mikroskopiertechniken vertraut zu machen. Klicken Sie hier, um direkt auf das Online-Handbuch zuzugreifen.
* QR-Code ist eine eingetragene Marke von DENSO WAVE INCORPORATED.


Jederzeit schnell und einfach verstaut
Bei der Entwicklung des Si hat man auch darauf geachtet, dass das Mikroskop nach getaner Arbeit schnell und sicher verstaut werden kann. Neben dem leichten, griffgünstigen Design hat das ansprechende Stativ auf seiner Rückseite auch eine praktische Vorrichtung fürs Aufwickeln des Stromkabels.
Leicht zu tragen
Das Stativ des ECLIPSE Si ist um 14% leichter als das des Vorgängermodells*. Griffmulden auf beiden Seiten der Mikroskopbasis und der hinteren Arme lassen das Mikroskop leicht und sicher tragen. Darüber hinaus können die Okulare mit Schrauben sicher befestigt werden, damit sie beim Transport nicht herunterfallen.
* Mit LED
Sicher verstauen
Zum Verstauen lässt sich der Tubus durch einfaches Lösen einer Feststellschraube nach hinten drehen, wodurch der Stauraum fürs Mikroskop nochmal kleiner wird. Der Tubus ist so konstruiert, dass er nach Lösen der Feststellschraube nicht herunterfallen kann. Die Drehrichtung für den Tubus ist deutlich auf dem Stativ angezeigt.
Auf der Rückseite des Mikroskops ist das Netzteil ordentlich in einem Fach verstaut und das Stromkabel auf die praktische Hantelspange gewickelt.



Optionales Zubehör
"Digital Sight" Mikroskopkamera DS 1000
Ausgestattet mit einem 2-Megapixel-CMOS-Bildsensor kann die Digital Sight 1000 hochauflösende 1920 x 1080 Pixel-Bilder und -Filme mit 30 Bildern / Sekunde anzeigen, aufnehmen und speichern. Schließen Sie einfach einen Monitor* und eine Maus an, und Sie können problemlos Bilder aufnehmen, ohne einen PC zu verwenden.
* Über ein HDMI-Kabel.


"Digital Sight" Mikroskopkamera DS-Fi3
Die DS-Fi3 hat einen 5,9-Megapixel-CMOS-Bildsensor, mit dem die Aufnahme hochaufgelöster Farb-Bilder mit bis zu 2880 x 2048 Pixel* möglich ist. Dieser neue CMOS-Bildsensor und die Hochgeschwindigkeits-Datenübertragung über USB 3.0 ermöglichen es mit der DS-Fi3, über die qualitativ hochwertige, hochaufgelöste Live-Bilddarstellung zu fokussieren und das Präparat am Monitor durchzumustern. Die hervorragende Farbreproduzierbarkeit ermöglicht die Aufnahme von Bildern mit Farben, die denen beim Blick durch die Okulare entsprechen. Aufgrund ihrer hohen Empfindlichkeit eignet sich die DS-Fi3 auch ideal für die Aufnahme von Fluoreszenzbildern.
* Für die Steuerung der Kamera ist die Imaging-Software NIS-Elements L erforderlich.

Spezifikationen
| ECLIPSE Si | |
|---|---|
| Optisches System | Unendlich-Optik-System CFI60 |
| Beleuchtung | Leuchtstarke, weiße LED-Beleuchtung (ECO-Beleuchtung)
|
| Fokussierung | Koaxialer Grob-/Feinfokus (beidseitig), Querrollenlager Fokushub: Auf 2 mm / Ab 13 mm Grob: 37,7 mm/U, Fein: 0,2 mm/U, Messwert: 2 μm Drehmomenteinstellring und vertikaler Anschlag einstellbar |
| Okulare | Mit Dioptrienausgleich
|
| Tuben |
|
| Objektivrevolver | Nach hinten geneigter 5-fach Revolver (am Stativ montiert) |
| Kreuztisch | Mechanischer Tisch mit Präparatehalter 2L Verfahrbereich: 76 (X) × 52 (Y) mm |
| Objektive | Achromat-Objektive CFI E Plan:
Kompatibel mit weiteren CFI60-Objektiven |
| Kondensor | Abbe-Kondensor, NA 1,25 Zentrier- und höhenverstellbar |
| Mikroskopiertechniken*5 | Hellfeld, Phasenkontrast, Durchlicht-Fluoreszenz, Dunkelfeld, einfache Polarisation |
| Anti-Schimmelpilz-Beschichtung | Antimykotische Beschichtung rund um das optische System |
| Optionales Zubehör |
|
| Stromversorgung | Netzteil: Eingang 100–240 VAC, Ausgang 5 VDC, max. 3,0 A |
| Leistungsaufnahme | Max. 5 W |
| Gewicht | 6,0 kg (Binokular), ca. 6,4 kg (Trinokular) |
*1 Bei einfachem Polarisator nur ein Filter möglich
*2 Für EC-T-TB2 oder EC-T-TF2 Tuben
*3 Für C-TB, C-TF, C-TT oder C-TE2 Tuben
*4 Nicht geeignet für Dunkelfeld
*5 Für andere Techniken als Hellfeld ist Zubehör erforderlich
Die Kameras Digital Sight DS 1000, DS-Fi3 und die Imaging-Software NIS-Elements L sind nicht für den klinischen Einsatz vorgesehen.
Technische Änderungen und Irrtümer vorbehalten.

